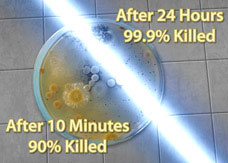
uv light installation

Ultraviolet Light
Protect Your Family!
Indoor Air Pollution is a Serious Threat
Pollen, mold, and bacteria are just a few of the microbial hazards that spread through the air. In fact the US Environmental Protection Agency now lists indoor air pollution as on of the major health risks of the 21st century.
How UV Light Works
Light produced by germicidal UV-C lamps penetrates the cell walls of micro-organisms present in your air handling system and alters the DNA molecule causing cellular damage, either killing the cells or preventing them from reproducing.
Kill Germs & Save Energy

Safe, effective, chemical-free disinfection
The Fresh-Aire UV line of germicidal UV light products from Triatomic Environmental provide safe, effective, disinfection in a variety of applications for your home or business. Save energy by keeping AC coils cleaner.
Germs in the Air You Breathe
Like it or not the air you breathe has a lot of stuff in it that you don’t want. Like viruses, bacteria, mold, mildew, and allergens. Some are only annoying, others can make you sick!
Because air passes repeatedly through your HVAC system (in fact many microbes like the cool dark damp interior of the system) this is the ideal place to intercept airborne pathogens and destroy them.
Germicidal UV-C applied to your central air system is a safe, economical, chemical-free way to significantly reduce airborne contaminants.
Your AC System Can Spread Airborne Pathogens
Your central air system keeps your family warm in the Winter and cool in the Summer. It works by re-circulating the air in your home, cooling or heating it a little each time it passes through the system.
Unfortunately this systems can also spread the worst sort of airborne pathogens throughout the house! Ordinary filters may trap some of these biohazards but few are killed; in fact the dark moist interior of the air handler is an ideal breeding ground for germs!
Commercial Systems benefits:
From large commercial buildings, strip malls or office space anywhere there is an air conditioning system a UV light can be added.


Fresh-Aire UV makes commercial UV air disinfection systems for structures large and small. These systems save money by reducing the need for chemical based air system cleaning. Even a small amount of mold on the cooling coils can significantly reduce air system energy efficiency.
A Commercial Series germicidal UV light system from Fresh-Aire UV works around the clock to keep the air system working at peak performance. This means energy and maintenance savings for building owners.
We also make UV disinfection systems for Ice Machines which can easily become contaminated with e-coli and other microbial pathogens.
![]()







